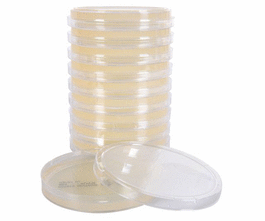
Potato Dextrose Agar (PDA), USP, for fungal cultures

Spectrum Chemical
Showing 55901–55950 of 78689 results
-

Potassium Vinyltrifluoroborate
$20.18 Add to cart View Product DetailsPotassium Vinyltrifluoroborate
-

Potassium Vinyltrifluoroborate
$45.44 Add to cart View Product DetailsPotassium Vinyltrifluoroborate
-
Potato Dextrose Agar (PDA), USP, for fungal cultures
$29.05 Add to cart View Product DetailsPotato Dextrose Agar (PDA), USP, for fungal cultures
-

Potato Dextrose Agar, 10 kg
$2,407.48 Add to cart View Product DetailsPotato Dextrose Agar, 10 kg
-

Potato Dextrose Agar, 5 kg
$1,229.67 Add to cart View Product DetailsPotato Dextrose Agar, 5 kg
-

Potato Dextrose Agar, 500 g
$130.13 Add to cart View Product DetailsPotato Dextrose Agar, 500 g
-

Potato Dextrose Broth, 10 kg
$2,040.65 Add to cart View Product DetailsPotato Dextrose Broth, 10 kg
-

Potato Dextrose Broth, 5 kg
$1,042.02 Add to cart View Product DetailsPotato Dextrose Broth, 5 kg
-

Potato Dextrose Broth, 500 g
$110.33 Add to cart View Product DetailsPotato Dextrose Broth, 500 g
-

Pouch Rack for all 15 in. chamber autoclaves
$269.56 Add to cart View Product DetailsPouch Rack for all 15 in. chamber autoclaves
-

Pouch Rack for all 9 in. and 10 in. chamber autoclaves
$232.24 Add to cart View Product DetailsPouch Rack for all 9 in. and 10 in. chamber autoclaves
-

Povidone K-30
$74.87 Add to cart View Product DetailsPovidone K-30
-

Povidone K-30
$172.87 Add to cart View Product DetailsPovidone K-30
-

Povidone K-30
$891.08 Add to cart View Product DetailsPovidone K-30
-

Povidone K-30, USP
$90.86 Add to cart View Product DetailsPovidone K-30, USP
-

Povidone K-30, USP
$164.70 Add to cart View Product DetailsPovidone K-30, USP
-

Povidone K-30, USP
$370.43 Add to cart View Product DetailsPovidone K-30, USP
-

Povidone K-30, USP
$2,432.11 Add to cart View Product DetailsPovidone K-30, USP
-

Povidone K-30, USP
$2,872.27 Add to cart View Product DetailsPovidone K-30, USP
-

Povidone K-30, USP
$10,135.49 Add to cart View Product DetailsPovidone K-30, USP
-

Povidone-Iodine, USP
$119.89 Add to cart View Product DetailsPovidone-Iodine, USP
-

Povidone-Iodine, USP
$367.28 Add to cart View Product DetailsPovidone-Iodine, USP
-

Povidone-Iodine, USP
$1,255.51 Add to cart View Product DetailsPovidone-Iodine, USP
-

Povidone-Iodine, USP
$2,968.04 Add to cart View Product DetailsPovidone-Iodine, USP
-

Povidone-Iodine, USP
$6,070.01 Add to cart View Product DetailsPovidone-Iodine, USP
-

Povidone, K-90, USP
$136.51 Add to cart View Product DetailsPovidone, K-90, USP
-

Povidone, K-90, USP
$423.17 Add to cart View Product DetailsPovidone, K-90, USP
-

Povidone, K-90, USP
$1,830.85 Add to cart View Product DetailsPovidone, K-90, USP
-

Povidone, K-90, USP
$6,113.85 Add to cart View Product DetailsPovidone, K-90, USP
-

Povidone, K-90, USP
$19,265.08 Add to cart View Product DetailsPovidone, K-90, USP
-

Powder Funnel, PP, Top Dia. (mm): 100 Stem Dia. (mm): 22, Length (mm): 94
$51.11 Add to cart View Product DetailsPowder Funnel, PP, Top Dia. (mm): 100 Stem Dia. (mm): 22, Length (mm): 94
-

Powder Funnel, PP, Top Dia. (mm): 120 Stem Dia. (mm): 27, Length (mm): 110
$62.05 Add to cart View Product DetailsPowder Funnel, PP, Top Dia. (mm): 120 Stem Dia. (mm): 27, Length (mm): 110
-

Powder Funnel, PP, Top Dia. (mm): 150 Stem Dia. (mm): 28, Length (mm): 138
$39.99 Add to cart View Product DetailsPowder Funnel, PP, Top Dia. (mm): 150 Stem Dia. (mm): 28, Length (mm): 138
-

Powder Funnel, PP, Top Dia. (mm): 65 Stem Dia. (mm): 15, Length (mm): 68
$33.19 Add to cart View Product DetailsPowder Funnel, PP, Top Dia. (mm): 65 Stem Dia. (mm): 15, Length (mm): 68
-

Powder Funnel, PP, Top Dia. (mm): 80 Stem Dia. (mm): 21, Length (mm): 75
$47.71 Add to cart View Product DetailsPowder Funnel, PP, Top Dia. (mm): 80 Stem Dia. (mm): 21, Length (mm): 75
-

Power Adapter and Universal Power Cord for mySPIN 6 High Speed mini centrifuge
$207.69 Add to cart View Product DetailsPower Adapter and Universal Power Cord for mySPIN 6 High Speed mini centrifuge
-

Power Adapter without plug for Compact Toploading Scales (must purchase US Plug Separately)
$79.35 Add to cart View Product DetailsPower Adapter without plug for Compact Toploading Scales (must purchase US Plug Separately)
-

Power Cord – 120V/10A (PC-200/210/220, 400/410/420)
$101.96 Add to cart View Product DetailsPower Cord – 120V/10A (PC-200/210/220, 400/410/420)
-

Power Supply (9V) for LABeler Lab Printer
$47.14 Add to cart View Product DetailsPower Supply (9V) for LABeler Lab Printer
-

POWER SUPPLY 110V BP =OR>12FG
$811.21 Add to cart View Product DetailsPOWER SUPPLY 110V BP =OR>12FG
-

Power supply for CPA26P, 120V/220V
$80.27 Add to cart View Product DetailsPower supply for CPA26P, 120V/220V
-

Power supply for Cubis, 100-240V
$336.38 Add to cart View Product DetailsPower supply for Cubis, 100-240V
-

Power supply for ME36S, 120V/220V
$478.69 Add to cart View Product DetailsPower supply for ME36S, 120V/220V
-

Power Units (pkg 12)
$154.10 Add to cart View Product DetailsPower Units (pkg 12)
-

PP Beakers with Handle and Spout, 2000 mL
$126.79 Add to cart View Product DetailsPP Beakers with Handle and Spout, 2000 mL
-

PP Beakers with Handle and Spout, 250 mL
$132.38 Add to cart View Product DetailsPP Beakers with Handle and Spout, 250 mL
-

PP Beakers with Handle and Spout, 3000 mL
$109.76 Add to cart View Product DetailsPP Beakers with Handle and Spout, 3000 mL
-

PP Funnel, Top Dia. (mm): 120, Stem Dia. (mm): 11, Length (mm): 180
$59.23 Add to cart View Product DetailsPP Funnel, Top Dia. (mm): 120, Stem Dia. (mm): 11, Length (mm): 180
-

PP Funnel, Top Dia. (mm): 30, Stem Dia. (mm): 1.5, Length (mm): 45
$26.02 Add to cart View Product DetailsPP Funnel, Top Dia. (mm): 30, Stem Dia. (mm): 1.5, Length (mm): 45
-

PP Funnel, Top Dia. (mm): 40, Stem Dia. (mm): 4, Length (mm): 65
$30.94 Add to cart View Product DetailsPP Funnel, Top Dia. (mm): 40, Stem Dia. (mm): 4, Length (mm): 65






